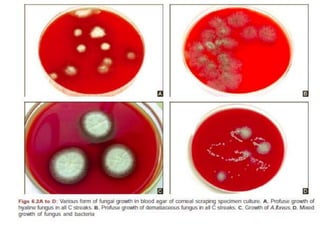
• A definitive diagnosis of fungal keratitis is made if
1. Corneal scrapings reveal fungal elements in smears,
2. Fungus grows in more than one medium in the
absence of fungus in smears,
3. Fungus grows on a single medium in the presence
of fungus in smears,
4. Confluent growth of fungus appears at the
inoculated site on a single solid medium.
• incubated for 10 days to facilitate sporulation.
• +ve test yielded : 3 days (83%) ,>1 wk(97%).
• no growth :in 1 wk & reported in 3 wks
• identification based on its macroscopic and
microscopic features.
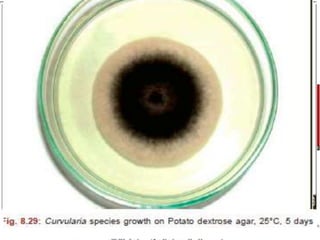
• MICROSCOPIC EXAMINATION METHODS
• direct examination of a portion of slide
• adhesive tape technique
• slide culture technique

Fungal corneal ulcers are common, caused mainly by Aspergillus in India. Risk factors include ocular trauma, contact lens use, pre-existing eye conditions, and systemic immunosuppression. Diagnosis involves corneal scrapings, cultures, and stains showing fungal hyphae or spores. Treatment consists of topical natamycin or amphotericin B, sometimes with adjunctive debridement, intracameral/intracorneal injections, or therapeutic keratoplasty for severe cases. Systemic antifungals may also be used for extensive infections.